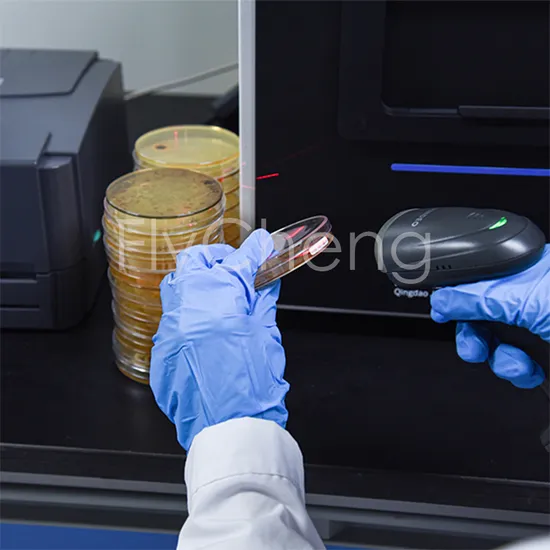

Preview
基本信息产品详情证书
基本信息
| 型号编号 | FC-ACC1101 |
| 使用说明 | 通用计数器 |
| 功能 | 菌落计数器 |
| 理论 | 数字的 |
| 携程模式 | 同步计数器 |
| 携基 | 模块n同步计数器 |
| 机制 | 电子的 |
| PLC 类型 | 西门子可编程逻辑控制器 |
| 计数速度 | 1000个菌落<1秒 |
| 色温 | 2880K至4170K |
| 上方光源 | 亮度:51.7-985.1勒克斯 |
| 下光源 | 360度无影照明 |
| 侧视图 | 1-4497 卢克斯底 |
| 图像捕获 | 自动对焦 |
| 培养皿类型 | 各种90毫米、100毫米的Petri培养皿 |
| 自动杂质去除 | 自动的 |
| 菌落形态分析 | 自动的 |
| 工作温度 | 摄氏0至50度 |
| 主机大小 | (L390×w390×h535)毫米 |
| 主机重量 | 大约13.4公斤 |
| 功率消耗 | 低于72W |
| 电源适配器 | 输入:AC100~240V 50/60Hz |
| 输出 | DC24V 1A |
| 交通总包 | 木制包装 |
| 规格 | 12百万像素 |
| 商标 | 飞成 |
| 起源 | 中国 |
| 生产能力 | 五千 |
产品详情
证书
标题:发酵罐证书

Preview


 青岛
青岛  已认证
已认证

